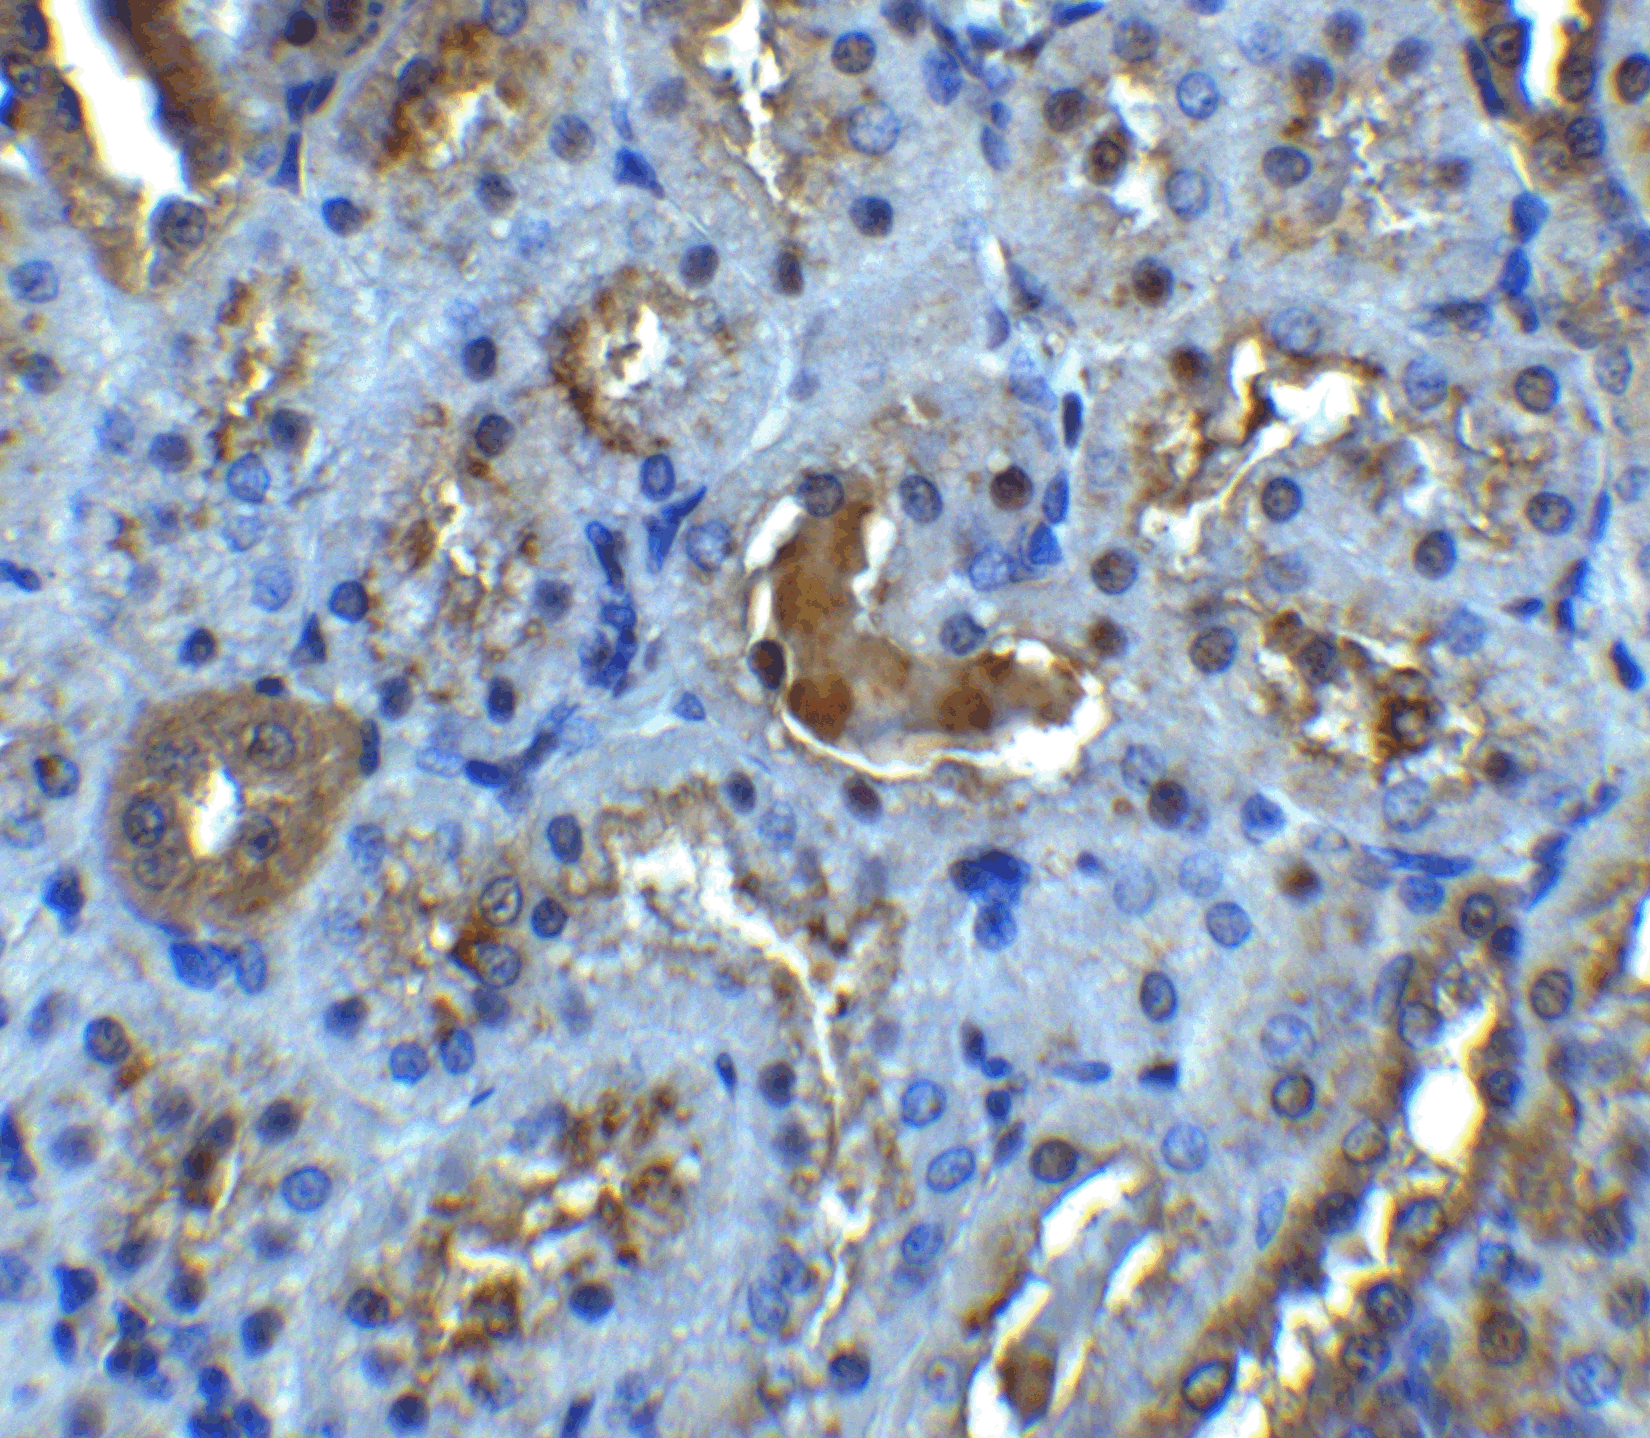
Immunohistochemistry of IL-22R in rat kidney tissue with IL-22R antibody at 5 μg/mL. Immunohistochemistry of IL-22R in rat kidney tissue with IL-22R antibody at 5 μg/mL.

IL-22 Receptor Antibody
Product Code:
PSI-2497
PSI-2497
Host Type:
Rabbit
Rabbit
Antibody Isotype:
IgG
IgG
Antibody Clonality:
Polyclonal
Polyclonal
Regulatory Status:
RUO
RUO
Applications:
- Enzyme-Linked Immunosorbent Assay (ELISA)
- Immunofluorescence (IF)
- Immunohistochemistry (IHC)
- Western Blot (WB)
No additional charges, what you see is what you pay! *
| Code | Size | Price |
|---|
| PSI-2497-0.02mg | 0.02mg | £150.00 |
Quantity:
| PSI-2497-0.1mg | 0.1mg | £453.00 |
Quantity:
Prices exclude any Taxes / VAT
Stay in control of your spending. These prices have no additional charges to UK mainland customers, not even shipping!
* Rare exceptions are clearly labelled (only 0.14% of items!).
* Rare exceptions are clearly labelled (only 0.14% of items!).
Multibuy discounts available! Contact us to find what you can save.
This product comes from: United States.
Typical lead time: 14-21 working days.
Contact us for more accurate information.
Typical lead time: 14-21 working days.
Contact us for more accurate information.
- Further Information
- Documents
- Related Products
- Show All
Further Information
Additional Names:
IL-22 Receptor Antibody: IL22R, CRF2-9, IL22R1, IL22R, Interleukin-22 receptor subunit alpha-1, Cytokine receptor class-II member 9, IL-22 receptor subunit alpha-1
Application Note:
IL-22 receptor antibody can be used for detection of IL-22 receptor by Western blot at 0.5-1 μg/mL. Antibody can also be used for immunocytochemistry starting at 10 μg/mL and immunohistochemistry starting at 5 μg/mL. For immunofluorescence start at 10 μg/mL.???????????????
Antibody validated: Western Blot in human samples; Immunohistochemistry in rat samples; Immunocytochemistry in human samples and Immunofluorescence in human and rat samples. All other applications and species not yet tested.
Antibody validated: Western Blot in human samples; Immunohistochemistry in rat samples; Immunocytochemistry in human samples and Immunofluorescence in human and rat samples. All other applications and species not yet tested.
Background:
IL-22 Receptor Antibody: A novel cytokine, designated IL-TIF for IL-10 related T cell-derived inducible factor and IL-22, was recently identified. The receptor for IL-22 (IL-22R, also termed CRF2-9 and IL-TIF-R1 chain) is a new member of the class II cytokine receptor family. IL-22R forms a complex with IL-10 receptor beta chain and mediates IL-22 signaling. IL-22 and its receptor activate JAK-STAT signaling pathway. IL22R is expressed in normal liver and kidney and their cell lines HepG2 and TK-10. A soluble form of IL-22 receptor, also termed IL-22 binding protein (IL-22BP) and IL-22 receptor-alpha 2 (IL-22RA2), was identified very recently. IL-22BP prevents binding of IL-22 to the functional cell surface IL-22R complex and neutralizes IL-22 activity. LPS induces IL-22 expression, which indicates the role of IL-22 in inflammatory response.
Background References:
- Dumoutier L, Louahed J, Renauld JC. Cloning and characterization of IL-10-related T cell-derived inducible factor (IL-TIF), a novel cytokine structurally related to IL-10 and inducible by IL-9. J Immunol. 2000;164(4):1814-9.
- Dumoutier L, Van Roost E, Colau D, Renauld JC. ?Human interleukin-10-related T cell-derived inducible factor: molecular cloning and functional characterization as an hepatocyte-stimulating factor. Proc Natl Acad Sci USA. 2000 ;97(18):10144-9.
- Xie MH, Aggarwal S, Ho WH, et al. Interleukin (IL)-22, a novel human cytokine that signals through the interferon receptor-related proteins CRF2-4 and IL-22R. J Biol Chem. 2000;275(40):31335-9.
- Kotenko SV, Izotova LS, Mirochnitchenko OV, et al. Identification of the functional interleukin-22 (IL-22) receptor complex: J Biol Chem. 2001;276(4):2725-32.
Buffer:
IL-22 Receptor Antibody is supplied in PBS containing 0.02% sodium azide.
Concentration:
1 mg/mL
Conjugate:
Unconjugated
DISCLAIMER:
Optimal dilutions/concentrations should be determined by the end user. The information provided is a guideline for product use. This product is for research use only.
Homology:
Predicted species reactivity based on immunogen sequence: Mouse: (93%), Bovine: (88%)
Immunogen:
IL-22 receptor antibody was raised against a synthetic peptide corresponding to amino acids near the amino terminus of human IL-22 receptor precursor.
The immunogen is located within the first 50 amino acids of IL-22 Receptor.
The immunogen is located within the first 50 amino acids of IL-22 Receptor.
NCBI Gene ID #:
58985
NCBI Official Name:
interleukin 22 receptor, alpha 1
NCBI Official Symbol:
IL22RA1
NCBI Organism:
Homo sapiens
Physical State:
Liquid
PREDICTED MOLECULAR WEIGHT:
Predicted: 63 kDa
Observed: 65 kDa
Observed: 65 kDa
Protein Accession #:
NP_067081
Protein GI Number:
10719607
Purification:
IL-22 Receptor Antibody is affinity chromatography purified via peptide column.
Research Area:
Chemokines & Cytokines
Swissprot #:
Q8N6P7
User NOte:
Optimal dilutions for each application to be determined by the researcher.
Documents
Related Products
| Product Name | Product Code | Supplier | IL-22 Receptor Peptide | PSI-2497P | ProSci | Summary Details | |||||||||||||||||||||||||||||||||||||||||||||||||||||||||||||||||||||||||||||||||||||||||||||
|---|---|---|---|---|---|---|---|---|---|---|---|---|---|---|---|---|---|---|---|---|---|---|---|---|---|---|---|---|---|---|---|---|---|---|---|---|---|---|---|---|---|---|---|---|---|---|---|---|---|---|---|---|---|---|---|---|---|---|---|---|---|---|---|---|---|---|---|---|---|---|---|---|---|---|---|---|---|---|---|---|---|---|---|---|---|---|---|---|---|---|---|---|---|---|---|---|---|---|---|